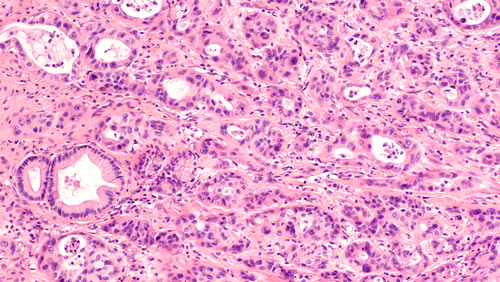

Combination immune checkpoint inhibition and SBRT for advanced pancreatic cancer: 2019 Gastrointestinal Cancers Symposium
Gastrointestinal Cancers Symposium News Jan 22, 2019
A phase I/II study sponsored by the National Cancer Institute lends support to further evaluating a potential new treatment strategy in advanced pancreatic adenocarcinoma (aPDAC)—more specifically, one that combines immune checkpoint inhibition and stereotactic body radiation therapy (SBRT).
Immune checkpoint inhibitors provide limited benefit in aPDAC, presumably because the tumour immune response has been stifled in the local tumour microenvironment. The investigators hypothesized that use of SBRT, which promotes antitumor immunity, either before or in tandem with PD-1/PD-L1 and CTLA-4 inhibitors, might provide the kick necessary to revive the immune system and enable the checkpoint inhibitors to successfully exert their therapeutic effects.
Toward this end, 51 patients with aPDAC have been enrolled in the study and separated into four treatment cohorts:
- Cohort 1 received monthly durvalumab, a PD-1 inhibitor, in combination with one upfront SBRT fraction
- Cohort 2 received five SBRT fractions followed by monthly durvalumab
- Cohort 3 received monthly durvalumab plus tremelimumab, a CTLA-4 inhibitor, in combination with one upfront SBRT fraction
- Cohort 4 received five SBRT fractions followed by monthly durvalumab and tremelimumab
Of 31 patients evaluated to date, one patient in Cohort 1 and two patients in Cohort 4 achieved a confirmed partial response, yielding an overall response rate of 9.6%.
Notably, the response in two of these three patients has lasted more than 12 months, suggesting durable activity. An additional seven patients across all cohorts demonstrated stable disease. No dose-limiting toxicities occurred with combined immune checkpoint inhibition and SBRT, but grade 3/4 lymphopenia and anaemia were reported.
This article is news of a study presented at the 2019 Gastrointestinal Cancers Symposium. Read the original here.
-
Exclusive Write-ups & Webinars by KOLs
-
Daily Quiz by specialty
-
Paid Market Research Surveys
-
Case discussions, News & Journals' summaries